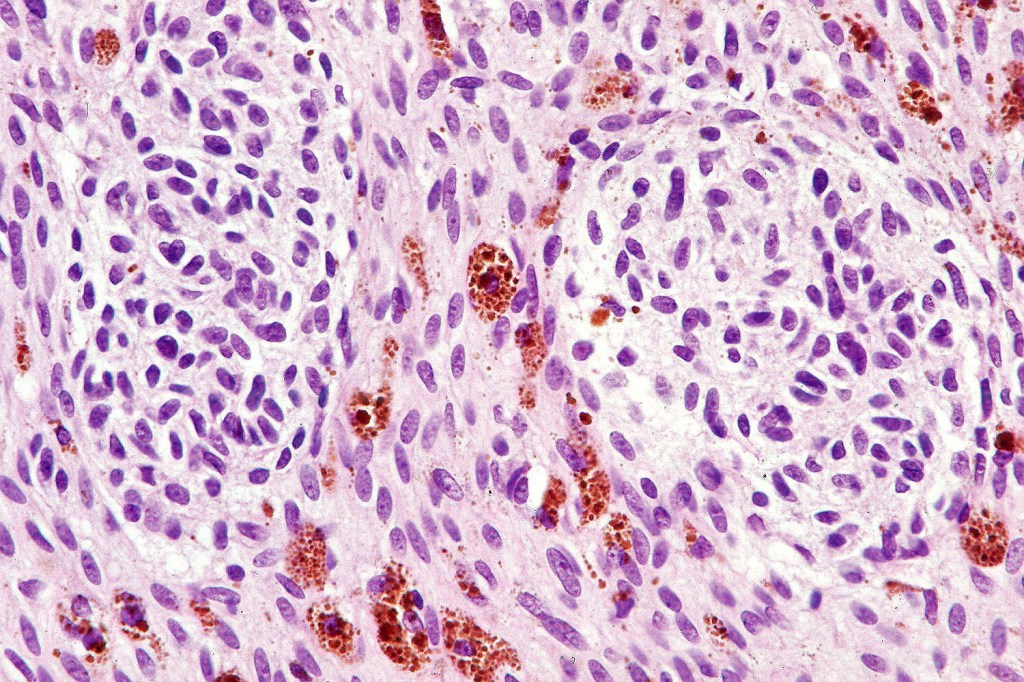
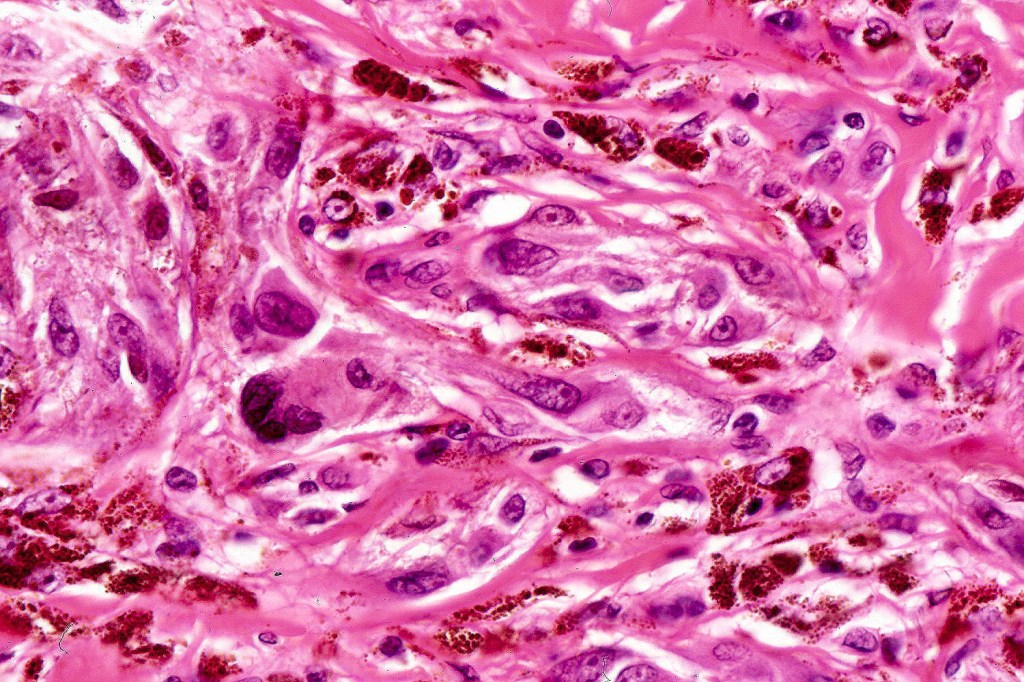
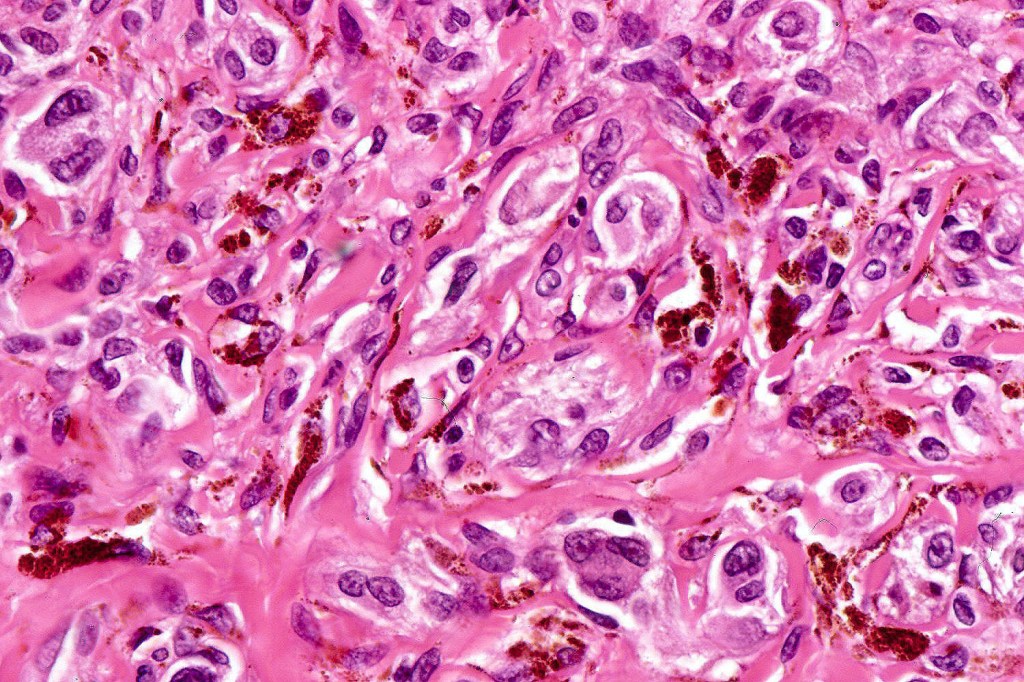
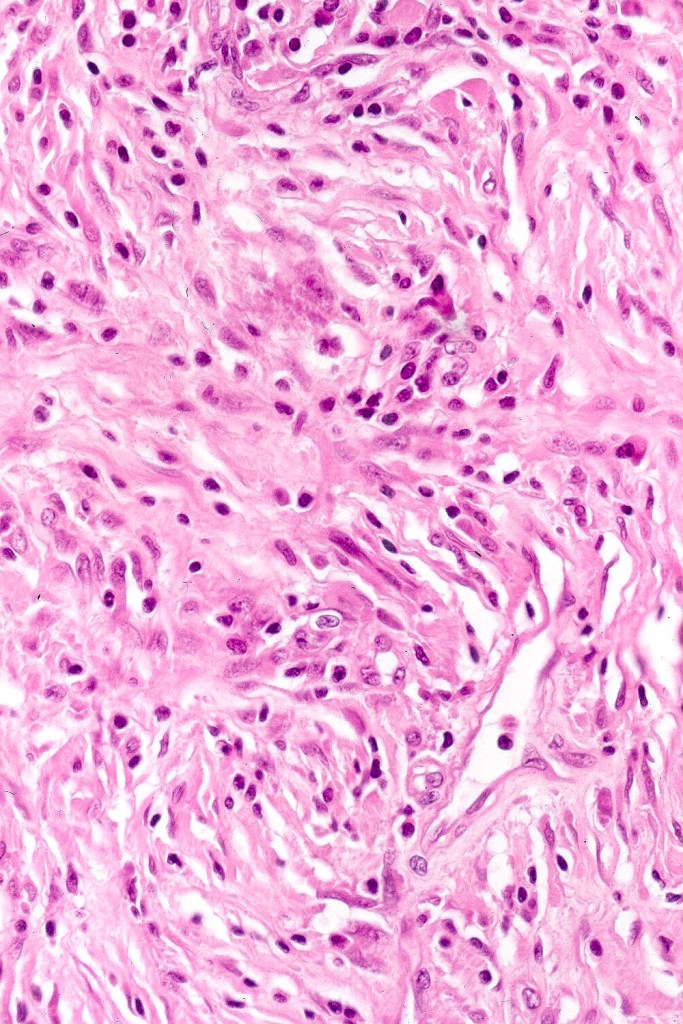
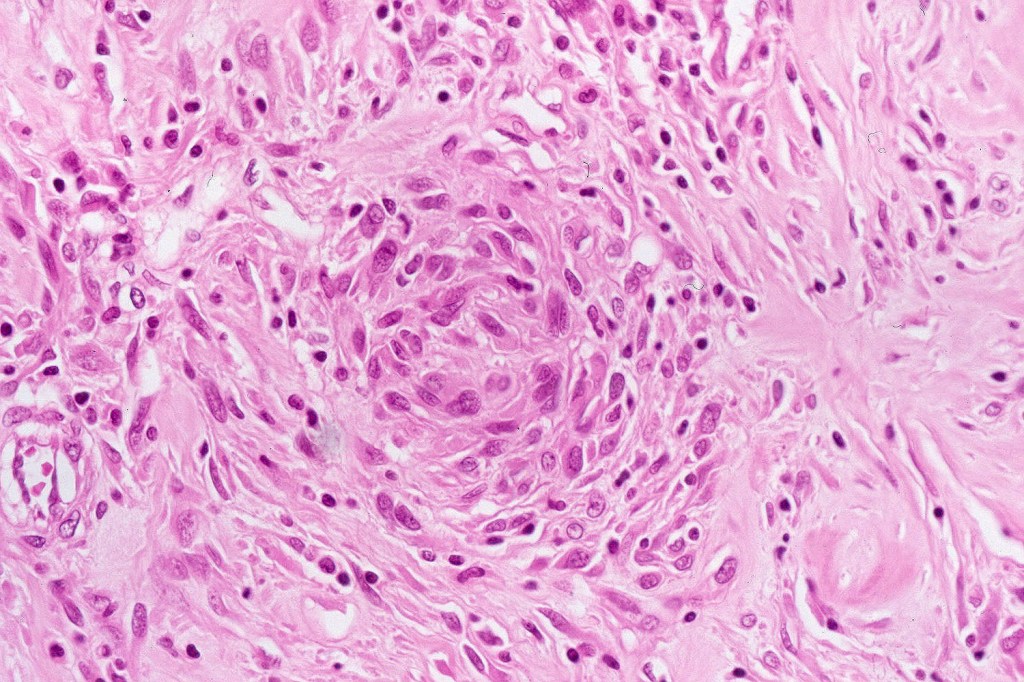

All of these lesions are thought to arise as a consequence of impaired migration of melanomcytes from the neural crest to the epidermis.
Lumbosacral congenital dermal melanocytosis (Mongolian blue spot, slate gray nevus)
Congenital dermal melanocytosis presents as an often large, slate blue colored lesion most often affecting the lumbar & sacral-gluteal region but can be more widespread. It is present at birth and fades with age. It is most commonly seen in Asian & Black chilldren. Hispanic children also show an increased incidence compared wtih Caucasiam children. It is quite benign and is of cosmetic importance only. In some patients there is an associated disorder of metabolism including lysosomal storage disease ( Hurler syndrome), GM1 infantile type 1 gangliosidosis, mucolipoidosisis type II & phakomatosis pigmentovascularis IIb.
Histologically the features are very subtle and may require a Masson Fontanna stain or immunohistochemistry for diagnosis. Small numbers of dendritic melanocytes are present in the deep dermis siad to be orientated parallel to the epidermis.



Nevus of Ota & Ito
Nevus of Ota (oculodermal melanosis) is a congenital slate blue lesion arising in the skin, mucosae & eye in the distribution of the opthalmic & maxillary branches of the trigeminal nerve. It may be bilateral and the Japanese are most often affected. Although it is often present at birth, it may arise later in childhood. There is a striking prediection for females (4:1). Ocular lesions involve the sclera, uvea & conjunctiva. The oral mucosa is sometimes involved. Meningeal melanocytosis may be present. Glaucoma is an important complication. Cases of ocular (4% of patients), cutaneous and meningeal melanoma have been docuemted.
In nevus of Ito, slate gray lesion is present in the disribution of the posterior supraclavicular & lateral branchial cutaneous nerves. Melanoma is a very exceptional complication.
Histologically, both lesions are characterized by the presence of denritic melanocytes in the upper & mid dermis. The overlying epidermis is often hperpigmented and increased numbers of melanocytes are sometimes evident.
Patch-like blue nevus overlaps the histology of congenital dermal melanocytosis and nevus of Ota.






Common blue nevus
Common blue nevus shows a predilection for the backs of the hands & feet, buttocks, face & scalp althought any site can be affected. It presents as a sharply delineated approximately 1.0 cm diameter slate blue or blue/black papulo/nodule. Congenital, eruptive, targetoid, plaque & desmoplatic/hypopigmented variants are recognised. Common blue nevi have also been described in the cervix, oral mucosa, conjunctiva & sclera, breast etc.
Exceptionally, melanoma is a complication
Histologically, it is characterized by a dense population of spindled, dendritic melnanocytes & melanophages with variable fibrosis. It may sometimes represent a component of a combined nevus. Mitotic activity is not usually present and pleomorphism is absent (see atypical blue nevus below). Involvement of the arrector pili muscle is not uncommon.
Very exceptionally, blue nevus also involves the epidermis (compound blue nevus).




























Cellular blue nevus
This uncommon most often devlops on the buttocks, sacrococcygeal region & distal extremities although it may be seen at just about any site. It shows a predilection for females and is diagnosed most often in the 2nd-4th decade. It presents as a blue-black/ or black nodule measuring 1-2 cm in dianeter. Similar to common blue nevus, the cellular variant can be encountered in a wide range of non-cutaneous locations.
Histological features
•Most characteristic is the dumbbell silhouette although a plague morphology may also be encountered
•Combined nevus variant
•Admixture of spindle cells, pigmented bipolar or dendritic cells & melanophages
•Cytoplasm is pale and nuclei are small with inconspicuous nucleoli
•An alveolar pattern is characteristic particularly with clear cell nodules
•Mitoses are typically very sparse or absent
•No atypical mitoses
•No Necrosis or lymphovascular invasion
•Multinucleate giant cells sometimes present
•Stromal fibrosis, myxoid change, vascular hyalinization with cyst formation are often seen
•Some tumors are composed spindle cells in a fascicular or neuronevoid pattern
•Perineural involvement may be seen
•Balloon cell change
•Desmoplastic variant
•Hypopigmented variant

Atpical blue nevus
This is exceedingly rare and the diagnosis should be used very sparingly. It is likely quite benign although very occasionally, a sentinel node biopsy is positive. Great care must be taken to make sure that a blue nevus-like melanoma isn’t missed. It shows the low power features of a blue nevus but high power scrutiny reaveals pleomorphism, nuclear hyperchromatism and increased mitotic activiy (<1 sq mm). Abnormal mitoses are absent as is necrosis. Perineural involvement can be seen but lymphovascular invasion is absent.

Neurocristic hamartoma
This is exceedinly rare and represents a hamartomatous lesion of neural crest origin The scalp is most often affected but although it can also present on the face, neck, buttock and elsewhere. It presents as folliculocentric brown or blue/black papules and nodules sometimes associated with alopecia. Exceptionally melanoma supervenes.
Histologically it presents in varying proprtions of banal and blue nevus accompanied by scattered dendritic cells associated with neurofibroma-like spindle cells and Schwann cell nodules with Meissner corpusces surrounded by sustentacular EMA positive cells. The lesion typically ensheathes the hair follicles.

Leave a comment